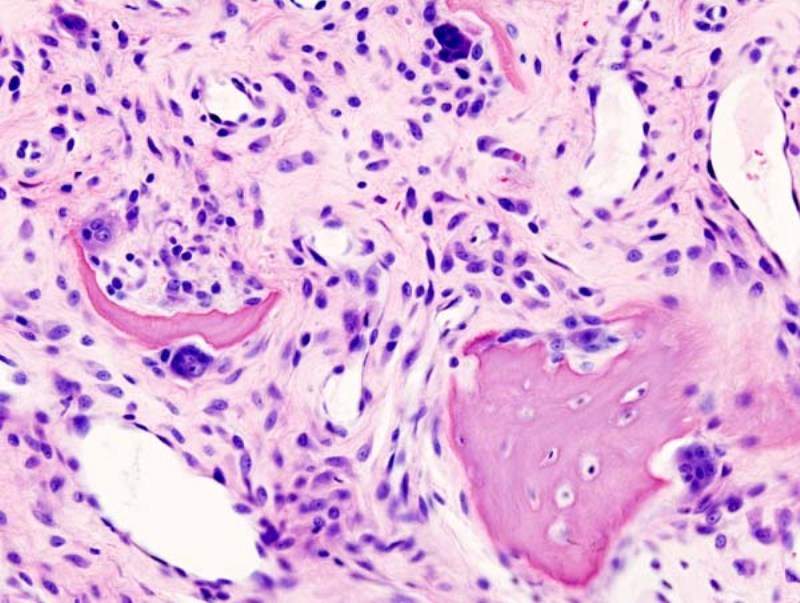

Aevi Genomic Medicine has reported negative results from the Phase II AEVI-001-ADHD-202 (ASCEND) trial after it failed to meet the primary endpoint of the study.
The dose-optimisation, parallel-group study evaluated AEVI-001 in children aged six to 17 with attention deficit hyperactivity disorder (ADHD) with or without an mGluR copy number variant.

Discover B2B Marketing That Performs
Combine business intelligence and editorial excellence to reach engaged professionals across 36 leading media platforms.
Primary endpoints of the trial included the reduction of ADHD-RS in the patients following six weeks of treatment with AEVI-001.
Results showed that AEVI-001 was safe and well tolerated with minimal adverse events reported among patients in both treatment groups.
Aevi Genomic Medicine CEO Michael Cola said: “We are very disappointed that the ASCEND trial did not achieve its primary endpoint.
“We plan to conduct a full review of the data with our scientific advisers in the coming days and consider our options.
“We will continue to focus on our pipeline of additional molecules, including AEVI-002 for severe pediatric-onset Crohn’s Disease and AEVI-005 for an undisclosed autoimmune orphan disease, both partnered with Kyowa Hakko Kirin.”
Aevi investigated orally-administered 100mg-400mg of AEVI-001 as part of the ASCEND trial.
The genomically-guided, double-blind, placebo-controlled study was conducted in two parts.
Part A of the trial included 69 subjects who have one of eight specific gene mutations implicated in glutamatergic signalling and neuronal connectivity.
Part B enrolled 109 subjects who did not have copy number variants (CNVs) in any of the specific gene mutations implicated in glutamatergic signalling and neuronal connectivity.
Both groups saw subjects randomised in 1:1 ratio to receive either AEVI-001 or placebo.
After being treated with the titrated dose of up to 400mg of AEVI-001, the participants entered a maintenance phase with weekly follow-up for up to six weeks.





